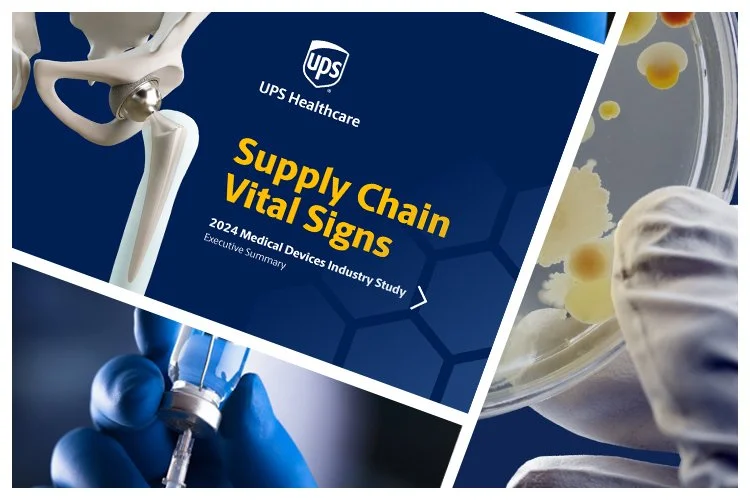
WEST-slider-UPS-Healthcare-Vital-Signs.jpg

Treat your brand like it’s the good news the world’s been waiting for.

Welcome to Waters Elliott Studio — you can call us WEST.
We’re a can-do partner with a flair for smart, efficient and effective marketing communications. And we’re all about doing what we call Brand Positive™ work.
People admire and support brands that live their values and speak and act with authenticity. Customers may know you, but do they know what you stand for? Because that’s a key to deeper engagement right there! Make your brand the very embodiment of your values and the sky’s the limit. Ready. Set…
So who are we?
We’re a purpose-built studio comprised of exceptional creative and strategic problem solvers that share a no-BS approach to marketing, design and advertising.
For you, that means no-hand-holding, less headaches and no fist-clenching-finger-crossing-OMG-I-hope-there’s-at-least-one-concept-on-strategy presentations. Sounds pretty positive so far, right?
So what do we do, anyway?
Technology, Logistics, Healthcare, Retail, Agri-Business and Heavy Equipment. We work in all these categories and strive for best-of-category work. Every time. We know our way around board rooms and factory floors. Job sites and e-commerce sites. Corn fields and clean rooms.
ADVERTISING
ANIMATION
BRAND IDENTITY
COLLATERAL DESIGN
CORPORATE TEAM APPAREL
DEALER KITS
DESIGN + COPY STYLE GUIDES
DIGITAL + SOCIAL CONTENT
DIRECT MAIL MARKETING
EMPLOYEE COMMUNICATION + AWARDS
EVENT DESIGN
PRODUCT VIDEOS
PUBLICATION DEVELOPMENT
RETAIL DISPLAYS / MERCHANDISING
SALES TOOLS & PRESENTATION
SUSTAINABILITY REPORTS
SALES VIDEOS
ADVERTISING ANIMATION BRAND IDENTITY COLLATERAL DESIGN CORPORATE TEAM APPAREL DEALER KITS DESIGN + COPY STYLE GUIDES DIGITAL + SOCIAL CONTENT DIRECT MAIL MARKETING EMPLOYEE COMMUNICATION + AWARDS EVENT DESIGN PRODUCT VIDEOS PUBLICATION DEVELOPMENT RETAIL DISPLAYS / MERCHANDISING SALES TOOLS & PRESENTATION SUSTAINABILITY REPORTS SALES VIDEOS

We’re proud to work with:






How to work with us? Any way you please, thank you.
We can start the relationship with just a project so you can get to know us and we can get to know you. Bring us along for bigger initiatives as your trust in us grows. We pride ourselves on swinging for the fences, but recognize that every initiative doesn’t have to be the World Series. We know how to be nimble and just “git ‘er done” when that’s what’s called for.